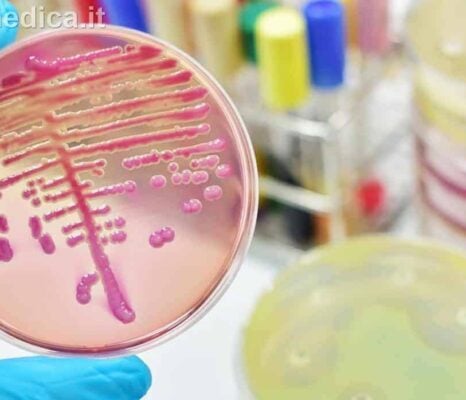
malattie infettive: streptococco, covid, omicron 5, influenza

una informazione sanitaria:
Tutto Sui Farmaci
Parafarmaci ed Integratori
Piante ed Erbe Medicinali
Alimentazione e Dietetica
Le Vitamine
Approfondimenti ed Articoli
Malattie Infettive
Calcolatori Medici
Utilità e Modelli di certificati medici
Medicina dei Viaggi
Il Nostro Studio Medico
Forum Torrinomedica
La nostra “mission”

Collaboratori
- Sandro Magnanelli
- Ada Maria Vetere
- Alessandro Gennari
- Elisa Magnanelli
- Elisa Migliozzi
- Alfonso Scarpa
- Andrea Militello
- Fabio Mazza
- Gabriele Antonini
- Pierpaolo Morosini
 Fondatore e CEO di Torrinomedica Medico laureato da 37 anni, Specialista in Medicina Interna ed Ematologia, con un’insana passione per l’informatica, che coltiva come hobby fin dal 1984
Fondatore e CEO di Torrinomedica Medico laureato da 37 anni, Specialista in Medicina Interna ed Ematologia, con un’insana passione per l’informatica, che coltiva come hobby fin dal 1984 Medico Specialista in Medicina Interna con 37 anni di laurea ed una inesauribile passione per la Medicina d’Urgenza
Medico Specialista in Medicina Interna con 37 anni di laurea ed una inesauribile passione per la Medicina d’Urgenza Responsabile SEO e Marketing. Laureato in Scienze della Comunicazione presso l’Università degli Studi di Siena Informatica generale – New media Informazione 2.0: tecnologia e organizzazione del lavoro
Responsabile SEO e Marketing. Laureato in Scienze della Comunicazione presso l’Università degli Studi di Siena Informatica generale – New media Informazione 2.0: tecnologia e organizzazione del lavoro Specialista in Medicina d’Emergenza-Urgenza Istruttore BLS e ACLS certificato American Heart Association Provider PALS American Heart Association Provider ATLS American College of Sourgeons Provider PTC Italian Resuscitation Council
Specialista in Medicina d’Emergenza-Urgenza Istruttore BLS e ACLS certificato American Heart Association Provider PALS American Heart Association Provider ATLS American College of Sourgeons Provider PTC Italian Resuscitation Council Specialista in Medicina d’Emergenza-Urgenza Dirigente Medico del DEA Policlinico Umberto I di Roma
Specialista in Medicina d’Emergenza-Urgenza Dirigente Medico del DEA Policlinico Umberto I di Roma Medico Specialista in Otorinolaringoiatria
Medico Specialista in Otorinolaringoiatria Medico Specialista in Urologia
Medico Specialista in Urologia Laurea Magistrale in Medicina e Chirurgia Laurea in Biologia Molecolare
Laurea Magistrale in Medicina e Chirurgia Laurea in Biologia Molecolare Medico Specialista in Urologia e Andrologia
Medico Specialista in Urologia e Andrologia Medico Chirurgo Specialista in Medicina Interna Specialista in Endocrinologia
Medico Chirurgo Specialista in Medicina Interna Specialista in EndocrinologiaIl Team di Torrinomedica
Avvertenze
Tutte le informazioni a carattere sanitario presenti nel sito, ove non altrimenti specificato, sono raccolte e curate dal Dr. Sandro Magnanelli e dalla Dr.ssa Ada Maria Vetere.
Nessuna organizzazione commerciale o non commerciale contribuisce al finanziamento, ai servizi o al materiale del sito, che si mantiene autonomamente grazie alle inserzioni pubblicitarie di Google AdSense.
Tali annunci pubblicitari sono ben evidenziati, differenziati per colore dal resto dei contenuti e posti fra due righe di colore grigio con la esplicita indicazione scritta di “Pubblicità” o di “Link Sponsorizzati” al di sopra.
Anche se la pubblicità è una fonte di finanziamento per il nostro sito, gli inserzionisti non hanno alcun diritto sul suo contenuto editoriale. Non sono ammesse inserzioni pubblicitarie a carattere osceno o non consono al contenuto professionale del sito, nè pubblicità di farmaci che non siano di libera vendita.